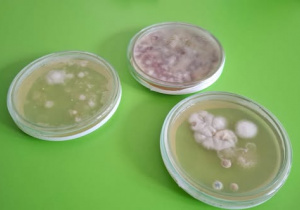
Naczynia z hodowlą bakterii.

Dzieje się na lekcjach biologii ...
Co naprawdę żyje na dłoniach naszych uczniów? Lekcja Biologii, która uczy higieny! Przeprowadziliśmy ekscytujące i bardzo pouczające doświadczenie: "Mikrobiom dłoni – co na mnie żyje?"Nasi uczniowie, wcielając się w mikrobiologów, sprawdzili, jakie mikroorganizmy zostawiali na specjalnych pożywkach:
- Zanim umyli ręce.
- Po kontakcie z różnymi powierzchniami.
- Po dokładnym umyciu rąk.
To doświadczenie to najlepsza wizualna lekcja o kluczowym znaczeniu prawidłowego i regularnego mycia rąk! Uczniowie na własne oczy zobaczyli różnicę i zrozumieli, jak ważne jest to dla zdrowia i odporności.
Na biologii budowaliśmy modele DNA, a na kolorowych patyczkach od lodów zgłębialiśmy chromosomową teorię dziedziczności. Brzmi poważnie? A to tylko jeden z wielu sposobów, w jakie nasi uczniowie uczą się przez działanie! Bo najlepiej zapamiętuje się to, co można dotknąć, skręcić i… połączyć w podwójną helisę.
Gazu, drożdże! Czyli jak mikroorganizmy nadmuchały balonik!
Na lekcji biologii uczniowie sprawdzili, jak drożdże „oddychają” bez tlenu. W kolbie powstał CO₂, który nadmuchał balonik! To właśnie fermentacja – proces, dzięki któremu rośnie ciasto i powstają bąbelki w napojach. Takie doświadczenia pokazują, że nauka to nie tylko teoria z podręcznika, ale prawdziwe odkrywanie świata przez działanie.
Uczniowie uczą się myśleć, obserwować i wyciągać wnioski - a to najcenniejsze umiejętności na przyszłość.